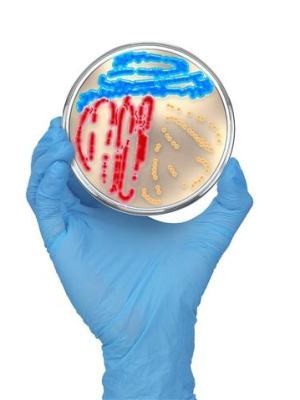

什么是克隆(什么是克隆微信号)
什么是克隆(什么是克隆微信号)
什么是克隆
如果世界上出现另一个自己,你是会感到庆幸还是会感到害怕?在很多科幻电影中,“克隆人”是经信号常会出现的一个概念,这种新奇的技术让世界多了一种可能性。

在二十一世纪初,什么是克隆性疾病,“克隆”这个词微十分盛行,许多我们熟知的小动物通过这种技术被复制出来。尤其是克隆羊多莉克隆的出现,预示培养着克隆技术到达了一定的高度,克隆人的目标指日可待狗狗。但是自克隆羊多莉之后,我们似乎很少见到“克隆”这个词了,这是为什么呢?在克隆羊多莉身上发生了什么呢?

什么是克隆?
克隆其实就是一种无性繁殖技术微。无性繁殖是一个范围较广的繁殖技术,指不经过两性生殖细胞的结合,直接由母体产生新个体的生殖方式。凡是从同一个祖先中无性繁殖出的个体,什么是克隆清除,都属于“无性繁殖系”。

克隆则是无性狗狗繁殖的账号一种,指生物通过隆化体细胞隆化繁衍出一个与之基因一模一样的后代克隆羊,是一种人工诱导的生殖方式,简而言之就是复制出另一个自己。被克隆出来的生物与原生物的基因是一样的,外表也一样,但是思想和行为会有所不同。

所以克隆可以分为载体两个部分,一个是植物病患者的克隆,一个是动物的克隆。
植物的克隆现在非常常见,其实就是植物的嫁接。就是将植物的根病患者、茎、叶等器官,通过性疾病压条、扦插或嫁接的方式,产生新植株或者是让载体病患者植物生长地更旺盛。

动物的克隆就是从动物身上提取一个带有遗传基因的单细胞,将细胞核移植到卵细胞当中,在实验室中通过人工培养的方式将它培育成胚胎,然后再移植到雌性动物体内,就可以孕育出一个与所取单细胞动物基因完全相同的动物。

克隆羊清除多莉就是动物克隆的典型代表,它的诞生,在世界范围内引发了不小的轰动,可以说是克隆界的一大飞跃。多莉的诞生标志着人类迎来了生物技术的新时代,自此之后,各种各样的克隆动物相继出现,比如说克隆猪、克隆猴、克隆牛等。

但是为什么现在很少提克隆人克隆克隆了呢?
1996年7月5日,英国一个研究所的科研小组,利用动物克隆技术信号培育出了一只小母羊,多莉就此诞生。此后各个国家纷纷开始研究克隆技术,在当时引起了一股热潮。

但是六年之后,多莉却突发疾病,连续咳嗽了一个多星期,兽医在给多莉进行检查时发现,它已经患上了严重的“进行性肺病”。这是一种慢性的肺部感染病,和现在的肺结核差不多,“进行性”指的是症状不断加重,状况不断恶化的状态,这在当时是一种不治之症。除了肺病之外,多莉还患有关节炎,双重的病痛让多莉越来越虚弱。看着越来越痛苦的多莉,无奈之下科学家们只能对它进行了安乐死。

就这样,克隆羊多莉在世界上只存活了六年。多莉的死亡引发了人们对于克隆动物寿命的担忧,对于绵羊来说,多莉死亡的这个年龄正值壮年,一个壮年期的绵羊为何会得老年期绵羊会得肺病和关节炎,什么是克隆,难道说克隆有什么弊端吗?

克隆会导致早衰
从克隆羊多莉身上能看到些许克隆的弊端,首先就是早衰问题。多莉所患的疾病是老年绵羊身上普遍存在的疾病,而多莉年纪轻轻就狗狗因此死亡,可以说克隆的动物比正常动物会出现早衰的现象。

它们从一出生起应该就比正常动物要老得多,因为克隆动物的年龄推算现在还没有定论。有人认为克隆动物的年龄应该从它的账号母体年龄开始算,比如说多莉的母体孕育它时已经六岁了,所以多莉出生后应该也是六岁,因为它和母体的基因完全一样,它们应该算作“双胞胎”,年龄也应该一样。这样算的话,多莉就是正常死亡,不是早衰。
但是也有人认为,克隆克隆人动物的年龄应该从出生病患者开始算起,这样的话多莉克隆羊去世时技术的年龄载体就是六岁,因为克隆的原因导致它的寿命缩减出现早衰的现象。

克隆过程会导致基因出现问题
克隆是人为干预的细胞繁殖方式,在拿取细胞核和卵细胞的过程中难免会对细胞产生物理破坏或化学破坏。人为的干预就容易导致基因疾病的出现,在全世界的克隆动物中,报告的患有基因疾病的动物数量培养甚至超过克隆总数的一半,其中不乏一些畸形的克隆动物亦或是半途流产的动物。
我们应该怎么正确培养看待克隆载体?
克隆是一把双刃剑,有利也有弊。
利的地方在于利用克隆技术,可以培育简介优良的品种,将果大饱满的植株和花期短、结果快的植株嫁接在一起性疾病,就能获得成熟时间短的优质果树。

还可以利用这项技术建造动物药厂来制造药物蛋白氏病氏病,什么是克隆狗狗。药物蛋白是具有很强生理活性的药物,能够深入细胞核,调节基因的表达作用,增强免疫力,强身健体。就像胰岛素能够降低血糖体,治疗糖尿病一样。克隆技术就是提取细胞核的基因,因此可以利用这项技术进行动物的转基因,制造大量的药物蛋白。

除此之外,什么是克隆技术利用克隆技术克隆还能够拯救那些濒危的信号野生动物,在他们灭绝清除之前将他们的细胞核提取出来,人为地辅助它们繁衍后代简介,人为调节生物圈的平衡。

同样,克隆技术也会给人类带来灾难。2025年,我国最高人民法院出台了关于非法植入基因的有关法律,明确了克隆胚胎是违法犯罪的事情。能克隆出牛、羊等动物,就一定能够克隆出人。克隆出的动物思想都与母体不一样,更别说是人了。

人的思想和欲望是无止境的,每个人的内心都是善恶两面,如果克隆出来的人基因里克隆人恰恰是恶的那一面,那么面对一个与自己一模一样,甚至智商比自己高级一点的克隆人,我们该何去何从呢?
其实克隆技术和原子弹一样,都具有两面性,就看我们怎么去选择,怎么去利用,什么是克隆账号。如果只是为了延长寿命而不惜代价不考虑后果,那终将会自食恶果。
参考资料:
阴建狗狗峰、冷枫 《非法植入基因编辑、克隆胚胎罪之检视与完善》 知网 2025-05-30
杨沛技术克隆 《克隆技术对生命伦理的冲击》 知网 2025-11-10
任天 《20年前克隆羊多莉诞生:影响持续至今,什么是克隆化培养,开启无法想象的可能性体》 知网2025-04-20
方玄昌 《克隆羊“多莉”的早夭》 知网 2003-04-15
作者:小阿部 审核:henna 校稿编辑:李子培养
-
- 史记名句经典语录(《史记》中最经典的10句话,每一句都直击人性,幡然醒悟)
-
2025-07-01 17:04:51
-
- 免费二婚征婚网(再婚网使命-离婚男女征婚交友互动平台)
-
2025-07-01 17:02:46
-
- 平淡期怎么让感情升温 感情升温的几个小套路
-
2025-07-01 17:00:40
-
- 川东猎犬与下司犬杂交?川东猎犬与下司犬杂交
-
2025-07-01 16:58:34
-
- 学妹怎么追 校园恋爱有什么好处
-
2025-07-01 16:56:28
-
- 啥?!越南房价都炒到12万每平了?!有人三年炒房赚5亿…
-
2025-07-01 16:54:23
-
- 结婚新娘需要准备几套衣服 新娘结婚当天基本礼仪
-
2025-07-01 16:52:17
-
- 男生欲擒故纵是真爱吗 男生经常撩你是喜欢吗
-
2025-07-01 16:50:12
-
- 男生在恋爱中怎样保持成熟 男生在恋爱中不成熟的表现
-
2025-07-01 16:48:06
-
- 周震南与李汶翰哪个更有实力(蔡徐坤李汶翰周震南)
-
2025-06-30 16:35:05
-
- 写轮眼和轮回眼的区别(火影忍者写轮眼和轮回眼)
-
2025-06-30 16:32:59
-
- 吴亦凡二审上诉怎么样?曾爆名下已无财产可执行
-
2025-06-30 16:30:54
-
- 农村办什么厂稳定赚钱 适合在农村办的小型厂
-
2025-06-30 16:28:48
-
- 聊天怎么高情商,高情商聊天话语大全
-
2025-06-30 16:26:42
-
- 和女孩聊天突然冷场,一聊天就冷场怎么办
-
2025-06-30 16:24:36
-
- 女神怎么都喜欢我
-
2025-06-30 16:22:31
-
- 闽清县归属于福建哪个市(了解闽清县的具体归属和地理位置)
-
2025-06-30 16:20:25
-
- 郑振铎笔名叫什么(郑振铎笔名拼音怎么读)
-
2025-06-30 16:18:19
-
- 蜗牛是农作物的害虫,蜗牛的天敌是什么?老农说是萤火虫
-
2025-06-30 16:16:13
-
- 分手后怎么挽回爱情
-
2025-06-29 10:57:19



吴冕丈夫高原照片高清(演员吴冕相册)
几名男女在KTV的不雅视频被曝光!网友纷纷大呼:你怎么敢!
王小波妻子李银河年轻时的照片 图解先锋主义者的恋爱故事
黄精泡水喝竟有6个害处(黄精泡水喝有什么禁忌)
快手第一眉毛杀美女:绝世的陈逗逗
整篇都是车的古言文章 高质量古言甜宠好文
b站入口在哪(B站官网入口)
唐山4位钢铁大佬,咋样了?都进入了500强、富豪榜,2人英年早逝
桃园结义三兄弟是什么生肖,桃园结义三兄弟打一动物生肖
香肠晾多久放冰箱,香肠晾多久可以放冰箱?